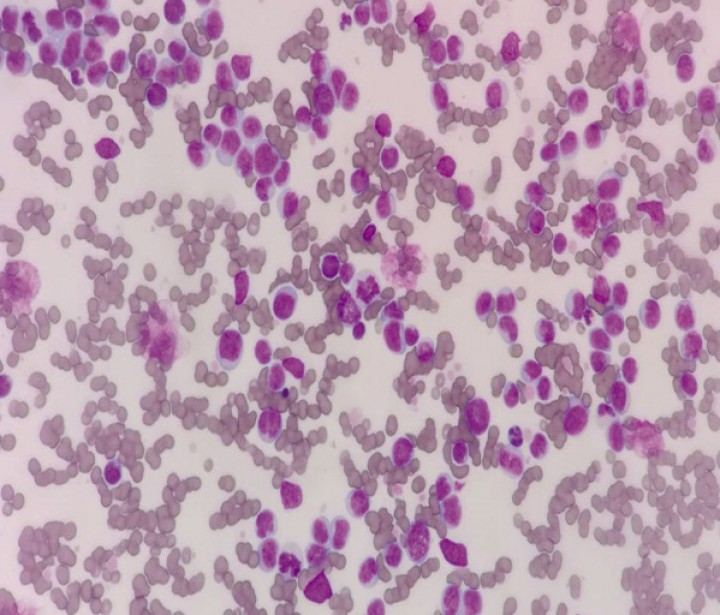
<p>Frotis sanguíneo en paciente felino con leucostasis. Nótese el elevado número de linfoblastos en el frotis de sangre. En este caso de linfoma mediastínico complicado con leucostasis el recuento total de células blancas en sangre periférica era de 349 970/μl (Diff-Quick, 100x).</p>

Resumen
En los últimos años nuestra capacidad para diagnosticar el cáncer se ha incrementado de forma considerable debido al acceso mayoritario a técnicas diagnósticas que antes sólo estaban al alcance de hospitales de referencia. De la misma forma, también se ha generalizado el uso en veterinaria de fármacos quimioterápicos, radioterapia o técnicas avanzadas de cirugía oncológica. Muchos de estos pacientes pueden presentarse en la consulta de urgencias debido a la presencia de signos clínicos graves que comprometen su vida. Dichos signos pueden estar asociados al propio tumor o al tratamiento instaurado para combatir el mismo. La capacidad del veterinario para reconocer de forma rápida la presencia de una neoplasia maligna en la consulta de urgencias, así como para instaurar un tratamiento adecuado lo antes posible puede tener un impacto significativo en la calidad de vida y la supervivencia de estos pacientes. La finalidad de este artículo es revisar algunas de las urgencias oncológicas comúnmente descritas en la literatura (hipercalcemia maligna, hipoglucemia, neutropenia febril, síndrome de lisis tumoral y síndrome de hiperviscosidad) con el fin de dotar al clínico de pequeños animales de las herramientas para su reconocimiento y manejo apropiado en urgencias, abordando su fisiopatología, presentación clínica, diagnóstico y tratamiento inmediato.
Abstract
In recent years, our ability to diagnose cancer has increased considerably, due to the access of most small animal clinicians to diagnostic techniques that in the past were only within reach of referral hospitals. Likewise, the use of chemotherapy, radiotherapy, and advanced oncologic surgical techniques has been generalized in veterinary medicine. Many of these patients can present in the emergency consult due to the presence of life-threatening clinical signs, which can be associated with the tumor itself or with its treatment. The ability to rapidly recognize the presence of a malignant neoplasia, and to establish a primary treatment plan in the emergency consult, can significantly impact the quality of life and survival of these patients. The aim of this paper is to provide the small animal clinician with the tools to recognize and adequately treat some commonly described oncologic emergencies (malignant hypercalcemia, hypoglycemia, neutropenic fever, tumor lysis syndrome and hyperviscosity syndrome), reviewing important aspects of their pathophysiology, clinical presentation, diagnosis and emergency treatment.

La presencia de este logo en un artículo de la revista indica que se publicará un examen sobre el mismo en la plataforma AVEPA Elearning. Su resolución aporta 0,15 créditos dentro del sistema de acreditaciones de especialidades veterinarias de AVEPA.
Introducción
El cáncer puede dar lugar a signos clínicos que comprometen la vida del paciente como resultado de la disfunción orgánica asociada al mismo o del tratamiento instaurado para combatirlo. En ocasiones, las alteraciones en la estructura o función orgánica que ocurren a distancia del tumor, denominadas en su conjunto síndromes paraneoplásicos, son la primera manifestación del cáncer y su identificación puede ser clave para llevar a cabo un diagnóstico correcto, al resultar característicos de determinados tipos de neoplasia. Por otra parte, la presencia de síndromes paraneoplásicos hace que muchos de estos pacientes se presenten por primera vez ante el veterinario en la consulta de urgencias debido a que afectan a los sistemas corporales principales (cardiovascular, respiratorio y neurológico). El objetivo de este artículo es revisar aspectos prácticos de la estabilización de estos pacientes y ayudar al clínico de pequeños animales a comprender conceptos clave de la fisiopatología de algunos síndromes paraneoplásicos, en particular aquellos de tipo metabólico y hematológico, con el fin de diagnosticar y tratar de manera eficiente al paciente con cáncer en la consulta de urgencias.
Hipercalcemia de malignidad
Fisiopatología
El cáncer es la causa más común de hipercalcemia en pequeños animales.[ Bergman PJ. Paraneoplastic syndromes. En Withrow SJ, Vail DM, Page RL (eds): Withrow & MacEwen´s Small Animal Clinical Oncology 5th edition, St Louis, Elsevier Saunders, 2013; 83-97. ] Diversos tumores pueden producir hipercalcemia de malignidad, siendo el más común el linfoma, especialmente el de tipo mediastínico.[ Bergman PJ. Paraneoplastic hypercalcemia. Topics in Compan An Med 2012; 27:156-158. ] Otras neoplasias en las que puede observarse una elevación de los niveles de calcio sérico son, entre otras: adenocarcinoma de glándulas apocrinas de los sacos anales, mieloma múltiple, tumores óseos, neoplasias de la glándula paratiroidea, tumores pulmonares primarios, timoma, angiomixoma renal, carcinoma tiroideo, carcinoma de células escamosas, melanoma, carcinoma y adenocarcinoma de glándula mamaria y leucemia linfocítica crónica.[ Bergman PJ. Paraneoplastic syndromes. En Withrow SJ, Vail DM, Page RL (eds): Withrow & MacEwen´s Small Animal Clinical Oncology 5th edition, St Louis, Elsevier Saunders, 2013; 83-97. ] Actualmente, se desconoce la prevalencia de hipercalcemia de malignidad en pacientes veterinarios, aunque se estima que es del 10-35% en perros con linfoma, de más del 25% en perros con adenocarcinoma de sacos anales y del 20% en perros con mieloma.[ Ross JT, Scavelli TD, Matthieson DT, Patnaik AK. Adenocarcinoma of the apocrine glands of the anal sac in dogs: a review of 32 cases. J Am Anim Hosp Assoc 1991; 27:349-355. ] En gatos, esta condición se ha descrito en enfermedades linfoproliferativas, carcinoma de células escamosas y mieloma múltiple.[ Savary KCM, Price GS, Vaden SL. Hypercalcemia in cats: a retrospective study of 71 cases (1991-1997). J Vet Intern Med 2000; 14:184-189. [PubMed] ]
Varios factores explican el aumento de calcio en pacientes con cáncer. Uno de ellos es la producción ectópica de parathormona (PTH)[ Nussbaum SR, Gaz RD, Arnold A. Hypercalcemia and ectopic secretion of parathyroid hormone by an ovarian carcinoma with rearrangement of the gene for parathyroid hormone. N Engl J Med 1990; 323:1324-1328. [PubMed] ] o, más comúnmente, de péptido relacionado con la parathormona (PTHrP) por el propio tumor. La similitud en la secuencia de aminoácidos de este péptido con la PTH sugiere que pueda actuar de forma similar a esta hormona en los tejidos óseo y renal, causando resorción osteoclástica y reabsorción renal de calcio. A diferencia de la PTH, el PTHrP no afecta a la absorción intestinal de calcio. La producción de este péptido se ha relacionado con la hipercalcemia de malignidad asociada a linfoma y adenocarcinoma de sacos anales.[ Weir EC, Burtis WJ, Morris CA et al. Isolation of 16000-dalton parathyroid hormone-like proteins from two animal tumors causing humoral hypercalcemia of malignancy. Endocrinology 1998; 123(6):2744-2751. [PubMed] ] Particularmente en el caso del linfoma y el mieloma múltiple, diversas citoquinas, como el factor de necrosis tumoral alfa (TNF-α), el ligando del receptor activador para el factor nuclear κB (RANKL) o la interleuquina 1beta (IL-1β), contribuyen al desarrollo de hipercalcemia en estos pacientes.[ Kohart NA, Elshafae SM, Breitbach JT, Rosol TJ. Animal models of cancer-associated hypercalcemia. Vet Sci 2017; 4(2):21. [PubMed] ]
Otro mecanismo de hipercalcemia de malignidad es la producción de factores locales que estimulan la actividad osteoclástica por parte de tumores óseos primarios o metástasis óseas de otras neoplasias, los cuales dan lugar a resorción ósea e hipercalcemia.[ Deftos LJ. Hypercalcemia in malignant and inflammatory diseases. Endocrinol Metab Clin North Am 2002; 31:141-158. [PubMed] ]
Presentación clínica
Las manifestaciones clínicas más importantes de la hipercalcemia de malignidad en perros son las asociadas a la alteración de la función renal. En general, la severidad de los signos clínicos se asocia al grado de elevación del nivel de calcio ionizado, aunque esta correlación no siempre se cumple, especialmente en gatos.[ Savary KCM, Price GS, Vaden SL. Hypercalcemia in cats: a retrospective study of 71 cases (1991-1997). J Vet Intern Med 2000; 14:184-189. [PubMed] ] El signo más característico en perros es la poliuriapolidipsia, y ésta se produce debido a una disminución de la respuesta a la hormona antidiurética (ADH) en el túbulo distal. A diferencia de los perros, los gatos con hipercalcemia raramente manifiestan poliuria-polidipsia. La elevación de los niveles de calcio también provoca una disminución del flujo sanguíneo renal y de la tasa de filtración glomerular, lo que da lugar a una elevación de los niveles de urea y creatinina.[ Bergman PJ. Paraneoplastic hypercalcemia. Topics in Compan An Med 2012; 27:156-158. ] Por otro lado, la deposición de sales de calcio en el parénquima renal también contribuye al empeoramiento de la función de este órgano.
Otros signos clínicos de hipercalcemia son vómitos, anorexia, estreñimiento, letargia y debilidad, particularmente en pacientes felinos. En casos severos puede apreciarse ataxia, alteración del estado mental, fasciculaciones musculares y convulsiones. En el examen físico puede detectarse bradicardia y el análisis del electrocardiograma puede revelar diversas alteraciones, como prolongación del intervalo PR, ensanchamiento del complejo QRS, acortamiento del intervalo QT y del segmento ST, y ensanchamiento de la onda T. En animales con hipercalcemia severa, la bradiarritmia asociada a este desequilibrio electrolítico puede evolucionar a bloqueo atrioventricular completo y asistolia.[ Green TA, Chew DJ: Calcium disorders. En Silverstein DC, Hopper K (eds): Small Animal Critical Care Medicine 2nd edition, St Louis, Elsevier Saunders, 2015; 274-280. ]
Diagnóstico
Aparte de las neoplasias citadas con anterioridad, otros diagnósticos diferenciales de hipercalcemia (Tabla 1) son: hipoadrenocorticismo, hiperparatiroidismo primario, enfermedad renal crónica, daño renal agudo, hipervitaminosis D, enfermedad granulomatosa, enfermedad ósea no neoplásica, de tipo iatrogénico e hipercalcemia idiopática (en gatos). También podemos encontrar elevaciones de calcio sérico en animales en crecimiento, de tipo postprandial y debidas a lipemia e hiperproteinemia.

Existen tres formas de calcio circulante en suero o plasma: ionizado o libre, unido a proteínas y formando complejos con fosfato, bicarbonato, lactato, citrato u oxalato. Debido a que la fracción de calcio ionizado es la biológicamente activa, el diagnóstico de hipercalcemia de malignidad debe basarse en una medición de esta forma de calcio. Dado que las fórmulas recomendadas para predecir la concentración de calcio ionizado a partir del calcio total sérico son imprecisas y pueden dar lugar a errores en el diagnóstico y manejo de estos pacientes,[ Green TA, Chew DJ: Calcium disorders. En Silverstein DC, Hopper K (eds): Small Animal Critical Care Medicine 2nd edition, St Louis, Elsevier Saunders, 2015; 274-280. ] la detección de un nivel elevado de calcio total debe ir siempre acompañada de una determinación de calcio ionizado con el fin de confirmar el diagnóstico de hipercalcemia.
Tratamiento
Debido a que la elevación de los niveles de calcio puede afectar a la función de órganos vitales, como el corazón, los riñones o el sistema nervioso central, la hipercalcemia constituye en sí una emergencia médica, especialmente en aquellos pacientes que desarrollen una hipercalcemia severa de forma aguda. La medición de los niveles de fósforo puede servir para guiar la terapia, debido a que un producto calcio-fósforo mayor de 60 puede predisponer a la mineralización de tejidos blandos. La terapia de hipercalcemia de malignidad incluye el tratamiento específico de la neoplasia, tan pronto como el paciente esté estable y se haya realizado el diagnóstico de la misma.
La terapia de urgencia para corregir la hipercalcemia debe incluir la utilización de uno o varios de los siguientes tratamientos: fluidoterapia intravenosa, diuréticos del asa (furosemida), glucocorticoides, calcitonina y bifosfonatos (Tabla 2). El fluido cristaloide de elección para el tratamiento de la hipercalcemia es el cloruro de sodio al 0,9%, debido a que el sodio inhibe de forma competitiva la reabsorción tubular de calcio, promoviendo por tanto la calciuresis. El cálculo de las necesidades de fluidoterapia debe incluir una rehidratación rápida (en 6-8 horas). Una vez el paciente ha sido correctamente hidratado, el uso de furosemida contribuye a la inhibición de la reabsorción de calcio en la rama ascendente del asa de Henle. Pueden utilizarse dosis de 1-2 mg/kg por vía intravenosa o subcutánea, cada 6-12 horas. El uso de furosemida en infusión continua intravenosa a 0,66 mg/kg/h en lugar de en bolos puede dar lugar a una mayor calciuresis y, por lo tanto, a un control más rápido y eficaz de la hipercalcemia.[ Adin DB, Taylor AW, Hill RC, Scott KC, Martin FG. Intermittent bolus injection versus continuous infusion of furosemide in normal adult Greyhound dogs. J Vet Intern Med 2003; 17:632-636. [PubMed] ] Es importante monitorizar el balance de fluidos al utilizar esta terapia, con el fin de evitar una excesiva contracción de volumen. Para ello, puede recurrirse a la medición de la producción de orina mediante la colocación de una sonda urinaria conectada a un sistema de recolección (Fig. 1).


Sondaje urinario. El uso de sondas urinarias Foley flexibles colocadas de forma estéril y unidas a un sistema de recolección cerrado permite la determinación sencilla de la producción de orina, así como el cálculo preciso de las necesidades de fluidoterapia en pacientes con oliguria o poliuria.
Los glucocorticoides pueden reducir el nivel de calcio sérico al disminuir la resorción ósea y la absorción intestinal y aumentar la excreción renal del mismo. Puede utilizarse dexametasona, a 0,1 mg/kg por vía intravenosa cada 12 horas, o prednisona, a 0,5-1 mg/kg por vía oral cada 12 horas. En aquellos casos en los que el origen de la hipercalcemia todavía no ha sido identificado, la terapia con glucocorticoides se considera contraindicada, debido a que el efecto citotóxico de los mismos sobre células redondas puede dificultar el diagnóstico de neoplasias como el linfoma o el mieloma múltiple. En casos raros que no respondan a la terapia anterior se puede recurrir al uso de calcitonina de salmón, la cual inhibe la actividad osteoclástica, a una dosis de 4-6 UI/kg por vía subcutánea cada 12 horas o bifosfonatos (pamidronato) a 1,3-2 mg/kg en infusión intravenosa lenta (2-4 horas) en 150 ml de cloruro de sodio al 0,9%.
Aunque se ha descrito un deterioro en la función renal en pacientes humanos tratados con pamidronato, dicho efecto no se observó en un estudio retrospectivo de 9 perros y 2 gatos tratados con este fármaco.[ Hostutler RA, Chew DJ, Jaeger JQ, Klein S, Henderson D, DiBartola SP. Uses and effectiveness of pamidronate disodium for treatment of dogs and cats with hypercalcemia. J Vet Intern Med 2005; 19:29-33. [PubMed] ] La terapia con bifosfonatos puede tardar días en inhibir por completo la resorción ósea de calcio, por lo que no se considera una opción adecuada como terapia única en una crisis aguda de hipercalcemia.[ Guay DR. Ibandronate, an experimental intravenous bisphosphonate for osteoporosis, bone metastases, and hypercalcemia of malignancy. Pharmacotherapy 2006; 26(5):655-673. [PubMed] ]
Hipoglucemia paraneoplásica
Fisiopatología
La hipoglucemia se define por un nivel de glucosa en sangre menor de 60 mg/dl, aunque en muchos casos ésta no se acompaña de signos clínicos hasta que la glucosa no desciende por debajo de 50 mg/dl.[ Koenig A: Hypoglycemia. En Silverstein DC, Hopper K (eds): Small Animal Critical Care Medicine 2nd edition, St Louis, Elsevier Saunders, 2015; 352-357. ] El insulinoma o tumor secretor de insulina de células β pancreáticas es la causa más frecuente de hipoglucemia asociada a neoplasia en pequeños animales. Ejemplos de neoplasias de origen no pancreático en las que se ha reportado hipoglucemia son: linfoma, leiomioma, leiomiosarcoma, carcinoma/adenocarcinoma (especialmente los de origen hepático, pulmonar, renal y en las glándulas mamaria y salivar), melanoma oral, plasmocitoma, mieloma múltiple y hemangiosarcoma.[ Bergman PJ. Paraneoplastic syndromes. En Withrow SJ, Vail DM, Page RL (eds): Withrow & MacEwen´s Small Animal Clinical Oncology 5th edition, St Louis, Elsevier Saunders, 2013; 83-97. ] Estas neoplasias pueden causar hipoglucemia debido a diversos mecanismos, principalmente por un aumento de la utilización de la glucosa por el tumor, por fallo de la gluconeogénesis y la glucogenólisis hepáticas y por secreción de insulina o péptidos similares a la insulina (IGF-1 e IGF-2) por el propio tumor. Otros diagnósticos diferenciales de hipoglucemia (Tabla 3) son: sepsis, hipoadrenocorticismo, disfunción hepática, fármacos (xilitol, sulfonilurea, β-bloqueantes) e hipoglucemia de neonatos y razas miniatura.[ Koenig A: Hypoglycemia. En Silverstein DC, Hopper K (eds): Small Animal Critical Care Medicine 2nd edition, St Louis, Elsevier Saunders, 2015; 352-357. ]

Presentación clínica
Los signos clínicos son el resultado de la neuroglucopenia y del aumento de los niveles de hormonas contrarreguladoras en sangre (glucagón, epinefrina, cortisol y hormona de crecimiento). Los signos más comunes de hipoglucemia son de tipo neurológico (convulsiones, debilidad, letargia y ataxia). Por otro lado, la estimulación adrenérgica por la liberación de catecolaminas puede causar fasciculaciones musculares, temblores y cambios de comportamiento.[ Goutal CM, Brugmann BL, Ryan KA. Insulinoma in dogs: a review. J Am Anim Hosp Assoc 2012; 48:151-163. [PubMed] ] En el caso del insulinoma, la aparición de los signos clínicos depende del grado de hipoglucemia y de la rapidez de instauración de la misma. De hecho, es frecuente observar pacientes con insulinoma asintomáticos a pesar de presentar una hipoglucemia marcada, debido a su adaptación progresiva a niveles muy bajos de glucosa.[ Whitley NT, Drobatz KJ, Panciera DL. Insulin overdose in dogs and cats: 28 cases (1986-1993). J Am Vet Med Assoc 1997; 211(3):326-330. [PubMed] ]
Diagnóstico
La triada de Whipple recoge los criterios para el diagnóstico de hipoglucemia: signos clínicos compatibles, nivel bajo de glucosa en sangre y resolución de dichos signos con la corrección de la hipoglucemia. Los glucómetros portátiles pueden sobreestimar o subestimar los niveles de glucosa sérica, por lo que un nivel bajo de glucosa debe confirmarse por otro método.[ Koenig A: Hypoglycemia. En Silverstein DC, Hopper K (eds): Small Animal Critical Care Medicine 2nd edition, St Louis, Elsevier Saunders, 2015; 352-357. ] Por otro lado, también puede obtenerse un valor bajo de glucosa al no separar el suero o plasma de las células sanguíneas en un tiempo inferior a 30 minutos, debido al consumo de la misma por los glóbulos rojos. Por último, en casos de policitemia y leucocitosis marcadas también pueden obtenerse niveles falsamente disminuidos de glucosa en sangre, debido al mismo efecto.
En el caso del insulinoma, el diagnóstico se basa en la medición de la concentración de insulina en una muestra de sangre obtenida durante un episodio de hipoglucemia. Niveles de insulina altos o normales en presencia de hipoglucemia son indicativos de esta neoplasia. Ante una sospecha clara de insulinoma y niveles de insulina equívocos, puede recurrirse al cálculo del ratio insulina/glucosa modificado (AIGR):
AIGR = (insulina x 100) / (glucosa en plasma –30)
Un AIGR mayor de 30 es indicativo de insulinoma. En caso de obtenerse un nivel de glucosa en sangre menor de 30 mg/dl, se utiliza en la fórmula un denominador de 1. Es importante tener en cuenta que este ratio no es específico de insulinoma y que pacientes con otras causas de hipoglucemia pueden tener un AIGR mayor de 30.[ Caywood DD, Klausner JS, O´Leary TP et al. Pancreatic insulin-secreting neoplasms: clinical, diagnostic and prognostic features in 73 dogs. J Am Anim Hosp Assoc 1988; 24:577-584. ] La concentración de fructosamina en sangre puede utilizarse como indicador de hipoglucemia crónica, al reflejar las concentraciones de glucosa del paciente durante los últimos 10 días. Aunque el uso principal de esta proteína glicosilada es el diagnóstico de diabetes mellitus, diversos estudios indican que perros con insulinomas tienen niveles significativamente más bajos de fructosamina.[ Mellanby RJ, Herrtage ME. Insulinoma in a normoglycaemic dog with low serum fructosamine. J Small Anim Pract 2002; 43(11):506-508. [PubMed] ] Otros métodos para identificar la presencia de un nódulo pancreático son la ecografía, la tomografía computarizada, la escintigrafía y la exploración quirúrgica. En aquellos casos en los que un nódulo pancreático es identificado en la ecografía abdominal, el examen citológico de punciones con aguja fina ecoguiadas puede ser útil para confirmar el diagnóstico de insulinoma[ Alleman AR: Endocrine system. En Raskin RE, Meyer DJ (ed): Atlas of Canine and Feline Cytology, Philadelphia, WB Saunders, 2001; 385-399. ] (Fig. 2).

Citología de insulinoma. En la muestra, obtenida mediante punción con aguja fina ecoguiada de un nódulo pancreático, se observa un cluster de células epiteliales englobadas en una matriz basófila granular. Se aprecian 1-2 nucléolos y vacuolización citoplasmática, así como moderada anisocitosis y anisocariosis. Dichos hallazgos confirman la presencia de una neoplasia de origen neuroendocrino, en este caso un insulinoma debido a su localización en el páncreas (Diff-Quick, 100x).
Tratamiento
El tratamiento inicial de una crisis hipoglucémica, independientemente de la causa, es la administración de un bolo intravenoso de 0,5-1 ml/kg de dextrosa al 50% (0,25-0,5 g/kg) en una dilución 1:2 en cloruro de sodio al 0,9%, en un tiempo no inferior a 2 minutos. El objetivo del tratamiento es resolver los signos clínicos de hipoglucemia, para lo cual puede no ser necesario normalizar el nivel de glucosa en sangre. Una vez corregidos los signos de hipoglucemia debe suplementarse la fluidoterapia intravenosa con dextrosa al 2,5-5 %, con el fin de prevenir nuevos episodios de hipoglucemia hasta que la causa de la misma sea identificada y corregida.
En el caso de insulinomas u otras neoplasias secretoras de análogos de insulina, la administración de bolos o infusiones intravenosas con altos porcentajes de dextrosa pueden causar una hipoglucemia de rebote, debido a la estimulación de la liberación de insulina por el tumor. En estos casos, en la estabilización del paciente antes de la intervención quirúrgica puede recurrirse al uso de glucagón, glucocorticoides u octreotida. El glucagón (administrado en un bolo intravenoso de 50 ng/kg, seguido de una infusión continua a 5-10 ng/kg/min) ejerce un potente efecto hiperglucemiante, al estimular la glucogenólisis y la gluconeogénesis a nivel hepático.[
Fischer JR, Smith SAS, Harkin KR. Glucagon constant-rate infusion: a novel strategy for the management of hyperinsulinemic-hypoglycemic crisis in the dog. J Am Anim Hosp Assoc 2000; 36(1):27-32. [PubMed]
] La dexametasona fosfato sódico (0,1 mg/kg por vía intravenosa cada 12 horas) y la prednisolona (0,5-1 mg/kg por vía intravenosa cada 12 horas) antagonizan el efecto de la insulina y pueden utilizarse para controlar los niveles de glucosa en casos de hipoglucemia paraneoplásica, así como en el hipoadrenocorticismo. La octreotida, un análogo sintético de la somatostatina, ha mostrado un efecto beneficioso en el control de la glucemia y la disminución de los niveles de insulina en perros con insulinoma,[
Robben JH, van den Brom WE, Mol JA, van Haeften TW, Rijnberk A. Effect of octreotide on plasma concentrations of glucose, insulin, glucagon, growth hormone, and cortisol in healthy dogs and dogs with insulinoma. Res Vet Sci 2006; 80(1):25-32 [PubMed]
] a 20-40 μg/kg por
vía subcutánea cada 8 horas.[
Goutal CM, Brugmann BL, Ryan KA. Insulinoma in dogs: a review. J Am Anim Hosp Assoc 2012; 48:151-163. [PubMed]
]
Neutropenia febril
Fisiopatología
La neutropenia se define como un recuento inferior a 2900 neutrófilos/μl en perros e inferior a 2000 neutrófilos/μl en gatos.[ Claus MA. Febrile neutropenia. En Silverstein DC, Hopper K (eds): Small Animal Critical Care Medicine 2nd edition, St Louis, Elsevier Saunders, 2015; 466-472. ]
Los fármacos quimioterápicos, así como el uso de la radiación para el tratamiento de neoplasias, evitan la replicación celular e inducen apoptosis al dañar el ADN, lo cual afecta a células en crecimiento rápido y constante. Este efecto beneficioso para la terapia del cáncer da lugar a neutropenia, al provocar la depleción de células progenitoras de granulocitos en la médula ósea.[ Claus MA. Febrile neutropenia. En Silverstein DC, Hopper K (eds): Small Animal Critical Care Medicine 2nd edition, St Louis, Elsevier Saunders, 2015; 466-472. ]
La neutropenia es una importante complicación en pacientes que reciben quimioterapia debido a que los pone en riesgo de desarrollar graves infecciones, principalmente por parte de microorganismos de su propia microbiota gastrointestinal. En la mayoría de los casos la mielotoxicidad por fármacos quimioterápicos es autolimitante y no requiere hospitalización.[ Gustafson DL, Page RL: Cancer chemotherapy. En Withrow SJ, Vail DM, Page RL (eds): Withrow & MacEwen´s Small Animal Clinical Oncology 5th edition, St Louis, Elsevier Saunders, 2013; 157-179. ] No obstante, la aparición de esta complicación puede acarrear la interrupción del tratamiento o la reducción de la dosis del fármaco empleado, lo cual puede disminuir la eficacia del protocolo de quimioterapia. Un estudio caso-control reciente[ Sorenmo KU, Harwood LP, Drobatz KJ. Case-control study to evaluate risk factors for the development of sepsis (neutropenia and fever) in dogs receiving chemotherapy. J Am Vet Med Assoc 2010; 236:650-656. [PubMed] ] ha identificado los factores de riesgo para el desarrollo de neutropenia febril en perros tratados con quimioterapia: el tratamiento de animales de raza pequeña, el uso de vincristina o doxorubicina y la presencia de neoplasias hematológicas, principalmente el linfoma.
A pesar de considerarse un efecto negativo de la quimioterapia, algunos estudios en medicina humana han demostrado una correlación positiva entre la aparición de neutropenia y el pronóstico de determinados tumores.[ Tewari KS, Java JJ, Gatcliffe TA, Bookman MA, Monk BJ. Chemotherapy-induced neutropenia as a biomarker of survival in advanced ovarian carcinoma: An exploratory study of the Gynecologic Oncology Group. Gynecol Oncol 2014; 133:439-445. [PubMed] ] De forma similar, un estudio prospectivo en 50 perros con linfoma multicéntrico tratados con un protocolo CHOP[ Wang SL, Lee JJ, Liao AT. Chemotherapy-induced neutropenia is associated with prolonged remission duration and survival time in canine lymphoma. Vet J 2015; 205(1):69-73. [PubMed] ] identificó un incremento en los periodos de remisión y supervivencia en aquellos perros que habían desarrollado neutropenia a lo largo del tratamiento. Dicho hallazgo indica que la neutropenia inducida por la quimioterapia podría ser un indicador válido para predecir la respuesta a la misma.
Presentación clínica
La neutropenia inducida por mielosupresión, a diferencia de la provocada por excesiva demanda tisular, da lugar a infecciones con cambios mínimos en el examen físico, así como en pruebas complementarias como radiografías o urianálisis debido a la supresión de la respuesta inflamatoria por la falta de neutrófilos.[ Bodey GP. Unusual presentation of infections in neutropenic patients. Int J Antimicrob Agents 2000; 16:93-95. [PubMed] ] De hecho, muchos animales sépticos pueden no presentar fiebre o incluso tener hipotermia en su presentación inicial en urgencias. También es importante tener en cuenta la influencia de tratamientos previos (glucocorticoides o antiinflamatorios no esteroideos) en la ausencia de una respuesta febril. La taquicardia es un hallazgo frecuente en el examen físico de pacientes sépticos y puede estar causada por dolor, estrés, hipovolemia o la liberación de citoquinas.
La presencia de hipotensión es un factor pronóstico negativo bien reconocido en pacientes humanos con neutropenia febril, que ha mostrado una correlación significativa con la mortalidad en un estudio retrospectivo en perros.[ Britton BM, Kelleher ME, Gregor TP, Sorenmo KU. Evaluation of factors associated with prolonged hospital stay and outcome of febrile neutropenic patients receiving chemotherapy: 70 cases (1997-2010). Vet Comp Oncol 2014; 12(4):266-276. [PubMed] ] La hipotensión que no responde a la resucitación con fluidos recibe el nombre de shock séptico y puede ser debida a una mala distribución del flujo sanguíneo por vasodilatación, lo que requiere fármacos vasopresores, o a una disfunción sistólica miocárdica, que precisa de una terapia con fármacos inótropos (Fig. 3).

Monitorización de presión arterial en paciente en shock séptico. El uso de fármacos vasopresores e inótropos requiere la monitorización continua de la presión arterial de forma invasiva, mediante la colocación de un catéter arterial conectado a un monitor multiparamétrico.
Diagnóstico
El diagnóstico se basa en el recuento de leucocitos llevado a cabo mediante hemograma o frotis sanguíneo. La cantidad más baja o nadir de neutrófilos para la mayoría de los fármacos utilizados en oncología suele aparecer entre 7 y 10 días después de la administración de los mismos, aunque existen excepciones como el carboplatino, el cual da lugar a un doble nadir de neutrófilos aproximadamente los días 10 y 21 después de su administración.
Tratamiento
Actualmente no existe un protocolo estandarizado para el manejo de pacientes veterinarios con neutropenia febril. En general, se recomienda la hospitalización con fluidoterapia y tratamiento antibiótico parenteral (combinación de betalactámico y fluoroquinolona) en animales con fiebre y un recuento de neutrófilos menor de 750/μl. En estos casos, en ausencia de una infección documentada, la monitorización del número de neutrófilos puede llevase a cabo 3 días después del inicio de la terapia antibiótica, la cual puede ser interrumpida cuando el recuento de neutrófilos supere la cifra de 750/μl. El alta dependerá principalmente de la mejoría clínica del paciente y no del número de neutrófilos.
El uso de antibioterapia parenteral puede ser considerado en animales con un recuento de neutrófilos entre 750 y 1000/μl en presencia de uno o más de los siguientes factores de riesgo: neoplasias de origen hematológico, enfermedad concomitante, perros de raza Collie o positivos a la mutación ABCB1-1Delta (antigua MDR1) tratados con doxorubicina o alcaloides de la vinca y pacientes con un peso menor de 14 kg. Animales sin fiebre y con un recuento de neutrófilos superior a 1000/μl no requieren antibioterapia y pueden manejarse de forma ambulatoria, siempre que no existan signos gastrointestinales de importancia.[ Bisson JL, Argyle DJ, Argyle SA. Antibiotic prophylaxis in veterinary cancer chemotherapy: A review and recommendations. Vet Comp Oncol 2018; 16(3):301-310. [PubMed] ]
El factor estimulante de colonias de granulocitos recombinante canino (rcG-CSF) puede ser efectivo para acelerar la recuperación de la neutropenia asociada a quimioterapia en perros,[ Yamamoto A, Fujino M, Tsuchiya T, Iwata A. Recombinat canine granulocyte colony-stimulating factor accelerates recovery from cyclophosphamide-induced neutropenia in dogs. Vet Immunol Immunopathol 2011; 142:271-275. [PubMed] ] aunque su uso rutinario no se recomienda debido a su coste, limitada disponibilidad, posibilidad de efectos adversos y falta de estudios prospectivos que apoyen su uso.[ Fernandez-Varon E, Villamayor L. Granulocyte and granulocyte macrophage colony-stimulating factors as therapy in human and veterinary medicine. Vet J 2007; 174:33-41. [PubMed] ]
Debido a que estos pacientes pueden desarrollar infecciones causadas por la microbiota comensal, es importante extremar la higiene en su manejo hospitalario, lavándose las manos antes y después de tocar al animal y usando un gel desinfectante y guantes al manejar catéteres intravenosos, sondas urinarias y tubos de alimentación.[ Claus MA. Febrile neutropenia. En Silverstein DC, Hopper K (eds): Small Animal Critical Care Medicine 2nd edition, St Louis, Elsevier Saunders, 2015; 466-472. ]
En medicina veterinaria el conocimiento sobre los factores que determinan el pronóstico y la incidencia de complicaciones en el tratamiento de estos pacientes es limitado. En un estudio retrospectivo de 70 casos de neutropenia febril en perros tratados con quimioterapia,[ Britton BM, Kelleher ME, Gregor TP, Sorenmo KU. Evaluation of factors associated with prolonged hospital stay and outcome of febrile neutropenic patients receiving chemotherapy: 70 cases (1997-2010). Vet Comp Oncol 2014; 12(4):266-276. [PubMed] ] los factores asociados con una mayor duración de la hospitalización fueron la presencia de taquicardia u otros efectos adversos de la quimioterapia en el momento de la admisión, el tratamiento con G-CSF y el descenso del recuento de neutrófilos durante la hospitalización.
Síndrome de lisis tumoral
El síndrome de lisis tumoral se debe a la liberación masiva de contenido intracelular, principalmente fósforo, potasio y ácidos nucleicos, como resultado de la lisis de células tumorales después de un tratamiento con quimioterapia o radioterapia. En medicina humana, este síndrome se define por el desarrollo de 2 o más de las siguientes alteraciones bioquímicas: hiperpotasemia, hiperfosfatemia con hipocalcemia secundaria e hiperuricemia.[ Bickert B, Reilly A. Pediatric tumor lysis syndrome. J Pharm Pract 2004; 17:447-454. ] En medicina veterinaria este síndrome se ha descrito en el tratamiento de perros y gatos con linfoma[ Vickery KR, Thamm DH. Successful treatment of acute tumor lysis syndrome in a dog with multicentric lymphoma. J Vet Intern Med 2007; 21:1401-1404. [PubMed] ] y también después del tratamiento quirúrgico de un hemangiosarcoma[ Chohan AS, Greene SA. Anesthesia case of the month. Acute intraoperative tumor lysis. J Am Vet Med Assoc 2009; 234:746-749. [PubMed] ].
La aparición aguda de hiperpotasemia después del tratamiento con quimioterapia puede dar lugar a alteraciones en el electrocardiograma (bradicardia, onda T alta, prolongación del complejo QRS y disminución de la amplitud de la onda P), cuya gravedad no siempre está relacionada con el grado de elevación del nivel de potasio. El tratamiento de la hiperpotasemia incluye el uso de fluidos isotónicos para tratar la deshidratación y, en caso de oliguria en pacientes hidratados, furosemida. La terapia específica antiarrítmica incluye el gluconato cálcico al 10% para contrarrestar los efectos de la hiperpotasemia en el sistema de conducción, así como dextrosa con o sin insulina, bicarbonato sódico o fármacos agonistas β-adrenérgicos para disminuir la concentración de potasio sérico (Tabla 4).

La consecuencia clínica más importante de este síndrome es la aparición de daño renal agudo. En personas, el catabolismo hepático de las purinas genera ácido úrico y la precipitación de éste da lugar a obstrucción y daño de los túbulos renales. En perros, el metabolismo de las purinas a alantoína soluble hace que el daño renal asociado a la lisis tumoral se deba probablemente a la precipitación de fosfato cálcico en los tejidos blandos. El manejo del daño renal agudo asociado a este síndrome requiere la monitorización exhaustiva del balance de fluidos, la producción de orina, el nivel de electrolitos, el equilibrio ácido-base, el electrocardiograma y la presión arterial, siendo necesaria la terapia de reemplazo renal en casos de oliguria que no responde a la terapia con diuréticos o hiperpotasemia refractaria.[ Martin A, Acierno MJ. Continuous renal replacement therapy in the treatment of acute kidney injury and electrolyte disturbances associated with acute tumor lysis syndrome. J Vet Intern Med 2010; 24:986-989. [PubMed] ]
Síndrome de hiperviscosidad
En animales sanos la masa de eritrocitos es la principal determinante de la viscosidad sanguínea, mientras que el fibrinógeno es el responsable más importante de la viscosidad del plasma.[ Lewis MA, Hendrickson AW, Moynihan TJ. Oncologic emergencies: pathophysiology, presentation, diagnosis, and treatment. CA Cancer J Clin 2011; 61:287-314. [PubMed] ] El aumento de la viscosidad sanguínea puede deberse a un exceso de proteínas, principalmente inmunoglobulinas, o a una elevación marcada en el recuento de células sanguíneas (eritrocitos o leucocitos).
Hipergammaglobulinemia
En el caso del mieloma múltiple o el linfoma, la producción de una línea monoclonal de inmunoglobulinas por parte de las células neoplásicas puede dar lugar a signos clínicos de hiperviscosidad. Al aumentar su concentración estas proteínas se disponen formando agregados, lo cual incrementa la presión oncótica y la resistencia al flujo sanguíneo. Por otro lado, su carga positiva favorece la unión de los glóbulos rojos formando pilas de moneda, lo que dificulta el tránsito de los eritrocitos a través de los capilares, causando congestión microvascular y disminución de la perfusión tisular.[ Buxbaum J. Hyperviscosity syndrome in dysproteinemias. Am J Med Sci 1972; 264:123-126. [PubMed] ]
La alteración de la microcirculación cerebral se manifiesta principalmente por signos neurológicos[ Lewis MA, Hendrickson AW, Moynihan TJ. Oncologic emergencies: pathophysiology, presentation, diagnosis, and treatment. CA Cancer J Clin 2011; 61:287-314. [PubMed] ] (ataxia, alteración del estado mental y convulsiones). En el examen del fondo de ojo pueden detectarse dilatación de venas retinianas, papiledema, hemorragias y desprendimiento de retina.[ Menke MN, Feke GT, McMeel JW, Branagan A, Hunter Z, Treon SP. Hyperviscosity-related retinopathy in Waldenström macroglobulinemia. Arch Ophthalmol 2006; 124:1601-1606. [PubMed] ] El incremento de la viscosidad sérica puede aumentar el trabajo cardíaco y predisponer a fallo cardíaco congestivo en algunos pacientes. Por último, las inmunoglobulinas pueden interferir con la función de las plaquetas, lo que da lugar a la aparición de petequias y hemorragias en membranas mucosas.[ Mullen EC, Wang M. Recognizing hyperviscosity syndrome in patients with Waldenström macroglobulinemia. Clin J Oncol Nurs 2007; 11:87-95. [PubMed] ]
Estas proteínas pueden identificarse por electroforesis, aunque el diagnóstico de hiperviscosidad se basa en la identificación de los signos clínicos anteriores en pacientes con mieloma múltiple, linfoma, leucemia linfocítica o plasmocitoma extramedular.[ Forrester SD, Reeford RL. Serum hyperviscosity syndrome: Its diagnosis and treatment. Vet Med 1992; 1:48-54. ] El tratamiento se basa en tratar la causa primaria mediante quimioterapia. En casos graves puede recurrirse a la plasmaféresis para disminuir la viscosidad sérica reduciendo la carga de inmunoglobulinas.[ Lewis MA, Hendrickson AW, Moynihan TJ. Oncologic emergencies: pathophysiology, presentation, diagnosis, and treatment. CA Cancer J Clin 2011; 61:287-314. [PubMed] ]
Eritrocitosis
La eritrocitosis es un síndrome paraneoplásico poco frecuente, descrito en tumores renales, hepáticos y pulmonares, así como en linfoma, leiomiosarcoma cecal, fibrosarcoma nasal y tumor venéreo transmisible.[ Bergman PJ. Paraneoplastic syndromes. En Withrow SJ, Vail DM, Page RL (eds): Withrow & MacEwen´s Small Animal Clinical Oncology 5th edition, St Louis, Elsevier Saunders, 2013; 83-97. ] La eritrocitosis se debe a un aumento de la producción de eritropoyetina, a un exceso de la misma debido a hipoxia renal (detectada en las células del intersticio peritubular) o a la producción de factores inducidos por la hipoxia tumoral, como el HIF-1.[ Bergman PJ. Paraneoplastic syndromes. En Withrow SJ, Vail DM, Page RL (eds): Withrow & MacEwen´s Small Animal Clinical Oncology 5th edition, St Louis, Elsevier Saunders, 2013; 83-97. ] Otros diferenciales de policitemia son la deshidratación (eritrocitosis relativa), el hiperadrenocorticismo, enfermedades pulmonares o cardiacas que causen disminución de la saturación arterial de oxígeno (incluyendo comunicaciones cardiacas de derecha a izquierda) y la policitemia primaria o vera.
Los signos clínicos son debidos al tumor primario y al aumento de la viscosidad sanguínea, especialmente con hematocritos superiores al 70%. Los animales afectados pueden presentar mucosas hiperémicas y signos neurológicos, debido al compromiso de la microcirculación cerebral y a la formación de trombos (ataxia, ceguera, temblores, cambios de comportamiento y convulsiones). El aumento de la viscosidad también puede dar lugar a hipertensión y daño endotelial, los cuales pueden predisponer a hemorragias[ Giger U: Polycythemia and erythrocytosis. En Ettinger SJ, Feldman EC (eds): Textbook of Veterinary Internal Medicine 7th edition, St Louis, Saunders Elsevier, 2010; 279-283. ] (principalmente epistaxis e hipema).
El tratamiento de la eritrocitosis paraneoplásica requiere la escisión quirúrgica del tumor causante siempre que sea posible. También puede obtenerse una mejoría temporal de los signos clínicos mediante la reducción del valor hematocrito por flebotomía[ Giger U: Polycythemia and erythrocytosis. En Ettinger SJ, Feldman EC (eds): Textbook of Veterinary Internal Medicine 7th edition, St Louis, Saunders Elsevier, 2010; 279-283. ] (10-20 ml/kg, hasta conseguir un hematocrito por debajo del 55% en perros y del 50% en gatos). En caso de necesitar la retirada de un mayor volumen de sangre para conseguir dicho objetivo, puede recurrirse a la administración de cristaloides isotónicos o plasma con el fin de mantener la volemia.[ Bergman PJ. Paraneoplastic syndromes. En Withrow SJ, Vail DM, Page RL (eds): Withrow & MacEwen´s Small Animal Clinical Oncology 5th edition, St Louis, Elsevier Saunders, 2013; 83-97. ]
Leucostasis
El incremento de viscosidad sanguínea asociado a un elevado recuento de leucocitos recibe el nombre de hiperleucocitosis. Cuando este incremento da lugar a signos clínicos, principalmente neurológicos (ataxia, déficit de visión y alteración del estado mental) y dificultad respiratoria, se denomina leucostasis.[ Porcu P, Cripe LD, Ng EW et al. Hyperleucocytic leukemias and leukostasis: a review of pathophysiology, clinical presentation and management. Leuk Lymphoma 2000; 39:1-18. [PubMed] ] Dichos signos se asocian al enlentecimiento del flujo sanguíneo capilar y a la disrupción endotelial provocada por las células neoplásicas en el sistema nervioso central, la retina y el parénquima pulmonar.[ Lewis MA, Hendrickson AW, Moynihan TJ. Oncologic emergencies: pathophysiology, presentation, diagnosis, and treatment. CA Cancer J Clin 2011; 61:287-314. [PubMed] ] La aparición de signos clínicos es más probable con recuentos de leucocitos superiores a 200 000/μl (Fig. 4). En medicina humana la leucostasis se da principalmente en leucemias agudas, mientras que en veterinaria se ha descrito en una gata con linfoma mediastínico.[ De Membiela F, Del Portillo I, Francés R, Borrego JF. Leukostasis in a cat with mediastinal lymphoma. Proceedings of the 17th European Veterinary Emergency and Critical Care Congress; 2018 June 21-23; Venice, Italy, p. 299. ] El tratamiento consiste en la rápida citorreducción con quimioterapia, aunque en pacientes humanos con leucemia linfoblástica aguda, signos clínicos graves y recuentos de leucocitos por encima de 200 000/μl puede considerarse el uso de leucoféresis para disminuir el número de células neoplásicas en la circulación sanguínea.
Frotis sanguíneo en paciente felino con leucostasis. Nótese el elevado número de linfoblastos en el frotis de sangre. En este caso de linfoma mediastínico complicado con leucostasis el recuento total de células blancas en sangre periférica era de 349 970/μl (Diff-Quick, 100x).
Conclusión
El conocimiento de la fisiopatología y presentación clínica habitual de las formas comunes de cáncer que afectan a pequeños animales ofrece al veterinario de atención primaria en urgencias la posibilidad de llevar a cabo un diagnóstico rápido y un tratamiento apropiado de estos pacientes en la clínica, antes de ser potencialmente referidos a compañeros con especial dedicación a la Oncología. Un manejo inicial eficiente de complicaciones como azotemia, arritmias, hipoglucemia, fiebre o signos neurológicos asociados a hiperviscosidad, entre otras, puede tener un impacto decisivo en la supervivencia y posterior calidad de vida de pacientes con cáncer.
Fuente de financiación: este trabajo no se realizó con fondos comerciales, públicos o del sector privado.
Conflicto de intereses: los autores declaran que no existe conflicto de intereses.
Bibliografía
- [1] Bergman PJ. Paraneoplastic syndromes. En Withrow SJ, Vail DM, Page RL (eds): Withrow & MacEwen´s Small Animal Clinical Oncology 5th edition, St Louis, Elsevier Saunders, 2013; 83-97.
- [2] Bergman PJ. Paraneoplastic hypercalcemia. Topics in Compan An Med 2012; 27:156-158.
- [3] Ross JT, Scavelli TD, Matthieson DT, Patnaik AK. Adenocarcinoma of the apocrine glands of the anal sac in dogs: a review of 32 cases. J Am Anim Hosp Assoc 1991; 27:349-355.
- [4] Savary KCM, Price GS, Vaden SL. Hypercalcemia in cats: a retrospective study of 71 cases (1991-1997). J Vet Intern Med 2000; 14:184-189. [PubMed]
- [5] Nussbaum SR, Gaz RD, Arnold A. Hypercalcemia and ectopic secretion of parathyroid hormone by an ovarian carcinoma with rearrangement of the gene for parathyroid hormone. N Engl J Med 1990; 323:1324-1328. [PubMed]
- [6] Weir EC, Burtis WJ, Morris CA et al. Isolation of 16000-dalton parathyroid hormone-like proteins from two animal tumors causing humoral hypercalcemia of malignancy. Endocrinology 1998; 123(6):2744-2751. [PubMed]
- [7] Kohart NA, Elshafae SM, Breitbach JT, Rosol TJ. Animal models of cancer-associated hypercalcemia. Vet Sci 2017; 4(2):21. [PubMed]
- [8] Deftos LJ. Hypercalcemia in malignant and inflammatory diseases. Endocrinol Metab Clin North Am 2002; 31:141-158. [PubMed]
- [9] Green TA, Chew DJ: Calcium disorders. En Silverstein DC, Hopper K (eds): Small Animal Critical Care Medicine 2nd edition, St Louis, Elsevier Saunders, 2015; 274-280.
- [10] Adin DB, Taylor AW, Hill RC, Scott KC, Martin FG. Intermittent bolus injection versus continuous infusion of furosemide in normal adult Greyhound dogs. J Vet Intern Med 2003; 17:632-636. [PubMed]
- [11] Hostutler RA, Chew DJ, Jaeger JQ, Klein S, Henderson D, DiBartola SP. Uses and effectiveness of pamidronate disodium for treatment of dogs and cats with hypercalcemia. J Vet Intern Med 2005; 19:29-33. [PubMed]
- [12] Guay DR. Ibandronate, an experimental intravenous bisphosphonate for osteoporosis, bone metastases, and hypercalcemia of malignancy. Pharmacotherapy 2006; 26(5):655-673. [PubMed]
- [13] Koenig A: Hypoglycemia. En Silverstein DC, Hopper K (eds): Small Animal Critical Care Medicine 2nd edition, St Louis, Elsevier Saunders, 2015; 352-357.
- [14] Goutal CM, Brugmann BL, Ryan KA. Insulinoma in dogs: a review. J Am Anim Hosp Assoc 2012; 48:151-163. [PubMed]
- [15] Whitley NT, Drobatz KJ, Panciera DL. Insulin overdose in dogs and cats: 28 cases (1986-1993). J Am Vet Med Assoc 1997; 211(3):326-330. [PubMed]
- [16] Caywood DD, Klausner JS, O´Leary TP et al. Pancreatic insulin-secreting neoplasms: clinical, diagnostic and prognostic features in 73 dogs. J Am Anim Hosp Assoc 1988; 24:577-584.
- [17] Mellanby RJ, Herrtage ME. Insulinoma in a normoglycaemic dog with low serum fructosamine. J Small Anim Pract 2002; 43(11):506-508. [PubMed]
- [18] Alleman AR: Endocrine system. En Raskin RE, Meyer DJ (ed): Atlas of Canine and Feline Cytology, Philadelphia, WB Saunders, 2001; 385-399.
- [19] Fischer JR, Smith SAS, Harkin KR. Glucagon constant-rate infusion: a novel strategy for the management of hyperinsulinemic-hypoglycemic crisis in the dog. J Am Anim Hosp Assoc 2000; 36(1):27-32. [PubMed]
- [20] Robben JH, van den Brom WE, Mol JA, van Haeften TW, Rijnberk A. Effect of octreotide on plasma concentrations of glucose, insulin, glucagon, growth hormone, and cortisol in healthy dogs and dogs with insulinoma. Res Vet Sci 2006; 80(1):25-32 [PubMed]
- [21] Claus MA. Febrile neutropenia. En Silverstein DC, Hopper K (eds): Small Animal Critical Care Medicine 2nd edition, St Louis, Elsevier Saunders, 2015; 466-472.
- [22] Gustafson DL, Page RL: Cancer chemotherapy. En Withrow SJ, Vail DM, Page RL (eds): Withrow & MacEwen´s Small Animal Clinical Oncology 5th edition, St Louis, Elsevier Saunders, 2013; 157-179.
- [23] Sorenmo KU, Harwood LP, Drobatz KJ. Case-control study to evaluate risk factors for the development of sepsis (neutropenia and fever) in dogs receiving chemotherapy. J Am Vet Med Assoc 2010; 236:650-656. [PubMed]
- [24] Tewari KS, Java JJ, Gatcliffe TA, Bookman MA, Monk BJ. Chemotherapy-induced neutropenia as a biomarker of survival in advanced ovarian carcinoma: An exploratory study of the Gynecologic Oncology Group. Gynecol Oncol 2014; 133:439-445. [PubMed]
- [25] Wang SL, Lee JJ, Liao AT. Chemotherapy-induced neutropenia is associated with prolonged remission duration and survival time in canine lymphoma. Vet J 2015; 205(1):69-73. [PubMed]
- [26] Bodey GP. Unusual presentation of infections in neutropenic patients. Int J Antimicrob Agents 2000; 16:93-95. [PubMed]
- [27] Britton BM, Kelleher ME, Gregor TP, Sorenmo KU. Evaluation of factors associated with prolonged hospital stay and outcome of febrile neutropenic patients receiving chemotherapy: 70 cases (1997-2010). Vet Comp Oncol 2014; 12(4):266-276. [PubMed]
- [28] Bisson JL, Argyle DJ, Argyle SA. Antibiotic prophylaxis in veterinary cancer chemotherapy: A review and recommendations. Vet Comp Oncol 2018; 16(3):301-310. [PubMed]
- [29] Yamamoto A, Fujino M, Tsuchiya T, Iwata A. Recombinat canine granulocyte colony-stimulating factor accelerates recovery from cyclophosphamide-induced neutropenia in dogs. Vet Immunol Immunopathol 2011; 142:271-275. [PubMed]
- [30] Fernandez-Varon E, Villamayor L. Granulocyte and granulocyte macrophage colony-stimulating factors as therapy in human and veterinary medicine. Vet J 2007; 174:33-41. [PubMed]
- [31] Bickert B, Reilly A. Pediatric tumor lysis syndrome. J Pharm Pract 2004; 17:447-454.
- [32] Vickery KR, Thamm DH. Successful treatment of acute tumor lysis syndrome in a dog with multicentric lymphoma. J Vet Intern Med 2007; 21:1401-1404. [PubMed]
- [33] Chohan AS, Greene SA. Anesthesia case of the month. Acute intraoperative tumor lysis. J Am Vet Med Assoc 2009; 234:746-749. [PubMed]
- [34] Martin A, Acierno MJ. Continuous renal replacement therapy in the treatment of acute kidney injury and electrolyte disturbances associated with acute tumor lysis syndrome. J Vet Intern Med 2010; 24:986-989. [PubMed]
- [35] Lewis MA, Hendrickson AW, Moynihan TJ. Oncologic emergencies: pathophysiology, presentation, diagnosis, and treatment. CA Cancer J Clin 2011; 61:287-314. [PubMed]
- [36] Buxbaum J. Hyperviscosity syndrome in dysproteinemias. Am J Med Sci 1972; 264:123-126. [PubMed]
- [37] Menke MN, Feke GT, McMeel JW, Branagan A, Hunter Z, Treon SP. Hyperviscosity-related retinopathy in Waldenström macroglobulinemia. Arch Ophthalmol 2006; 124:1601-1606. [PubMed]
- [38] Mullen EC, Wang M. Recognizing hyperviscosity syndrome in patients with Waldenström macroglobulinemia. Clin J Oncol Nurs 2007; 11:87-95. [PubMed]
- [39] Forrester SD, Reeford RL. Serum hyperviscosity syndrome: Its diagnosis and treatment. Vet Med 1992; 1:48-54.
- [40] Giger U: Polycythemia and erythrocytosis. En Ettinger SJ, Feldman EC (eds): Textbook of Veterinary Internal Medicine 7th edition, St Louis, Saunders Elsevier, 2010; 279-283.
- [41] Porcu P, Cripe LD, Ng EW et al. Hyperleucocytic leukemias and leukostasis: a review of pathophysiology, clinical presentation and management. Leuk Lymphoma 2000; 39:1-18. [PubMed]
- [42] De Membiela F, Del Portillo I, Francés R, Borrego JF. Leukostasis in a cat with mediastinal lymphoma. Proceedings of the 17th European Veterinary Emergency and Critical Care Congress; 2018 June 21-23; Venice, Italy, p. 299.
Artículos recomendados
Estas recomendaciones se ofrecen de forma automática.
-
Evaluación de la ratio volumen atrio izquierdo/peso mediante el método sumatorio de discos en el corte paraesternal derecho 4 cámaras, en 205 pacientes
Ó. Monge-UtrillaClin Vet Peq Anim Vol. 44 - Nº 3 · SEP 2024 · Artículo original referido a múltiples casos clínicos -
Pérdida de consciencia en consulta de un paciente canino secundaria a rotura del atrio izquierdo
O. Monge-Utrilla, N. de Andrés-FernándezClin Vet Peq Anim Vol. 44 - Nº 1 · MAR 2024 · Artículo original referido a un solo caso clínico -
Mieloma múltiple en un gato con afectación extramedular de múltiples órganos abdominales
L. Magen-Moreno, D. Borràs-Murcia, G. Doria-TorraClin Vet Peq Anim Vol. 41 - Nº 2 · JUN 2021 · Artículo original referido a un solo caso clínico


